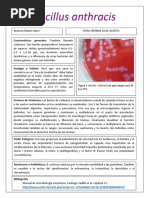

Clostridium botulinum
Clostridium botulinum
Taxonomía
Dominio: Bacteria
División: Firmicutes
Clase: Clostridia
Orden: Clostridiales
Familia: Clostridiaceae
Género: Clostridium
Especie: C. botulinum
� [editar datos en Wikidata]
Clostridium botulinum es el nombre de una especie de bacilo (Gram positiva anaerobia) que
se encuentra por lo general en la tierra y es productora de la toxina botulínica, el agente
causal del botulismo.1 Estos microorganismos tienen forma de varilla y se desarrollan mejor en
condiciones de poco oxígeno. Las bacterias forman esporas que les permiten sobrevivir en un
estado latente hasta ser expuestas a condiciones que puedan sostener su crecimiento.2
La espora es ovalada subterminal y deformante. Es móvil por flagelos peritricos, no produce
cápsula y es proteolítico y lipolítico. Son miembros del género Clostridium. Uno de los grupos
más numerosos entre las formas Gram positivas (C. botulinum) fue descubierta y aislada
en 1896 por Emile van Ermengem.3
Hay ocho tipos de toxinas botulínicas designadas por las letras A hasta la H; sólo
los Clostridium botulinum es un organismo de agua de un grado de salinización alto, sus
esporas pueden sobrevivir en la mayoría de los ambientes y son difíciles de destruir incluso a
la temperatura de ebullición del agua a nivel del mar, de modo que muchos enlatados son
hervidos a altas presiones para destruir las esporas.
El botulismo es una enfermedad de declaración obligatoria. Puede aparecer en cualquier
alimento de origen animal o vegetal, siendo las conservas, especialmente las caseras, los
lugares donde aparece en la práctica totalidad de los brotes. Las latas de conserva
deformadas que sueltan gas al abrirse es más que probable que estén contaminadas por C
botulinum, aunque esto no es un factor determinante.
El crecimiento de la bacteria puede ser prevenido con acidez, una alta concentración de
azúcar disuelto, altos niveles de oxígeno o poca humedad, disecando el producto o por medio
de una combinación de azúcar, concentración y gelificantes que hagan que el agua no esté
"disponible", tomando mediciones de actividad de agua (Aw). Un medio de baja acidez, como
por ejemplo los vegetales enlatados como las judías verdes, que no hayan sido calentados lo
suficiente para destruir las esporas, puede proveer un medio libre de oxígeno que le permita a
las esporas crecer y producir la toxina. Por el contrario, los tomates o salsas si son
suficientemente ácidos pueden prevenir crecimientos, aún si las esporas estuviesen
presentes, por tanto no presentan peligros para los consumidores. La miel, el jarabe de maíz y
otros aditivos dulces pueden contener las esporas de C botulinum, pero las esporas no
pueden crecer en soluciones con tan altas concentraciones de azúcares; sin embargo, cuando
el azúcar es diluido en el ambiente de bajo oxígeno y baja concentración como puede ser
el jugo gástrico de un infante, las esporas pueden desarrollarse y producir la toxina. Tan
pronto como los recién nacidos comienzan a consumir alimentos sólidos, el ácido gástrico es
suficiente para impedir el crecimiento de la bacteria. En neonatos, la enfermedad puede ser
secundaria a la colonización del colon por Clostridium botulinum.
Índice
[ocultar]
1Usos
o 1.1Bioarmamento
2Patogenia
3Referencias
4Enlaces externos
Usos[editar]
�En la industria alimentaria juega un papel perjudicial ya que la espora de esta bacteria es
termorresistente y puede sobrevivir a periodos de calor intenso incluso durante varias horas
de esterilización. La cepa de Clostridium botulinum es usada para la preparación de toxina
botulínica para fines cosméticos, usado principalmente para paralizar de manera selectiva
los músculos y temporalmente aliviar las arrugas faciales de origen dinámico. Además, esta
cepa de caracter estético tienen otros usos médicos, tales como el tratamiento del dolor facial
severo como el causado por neuralgia del trigémino.
Bioarmamento[editar]
Con la producción de la toxina botulínica por Clostridium botulinum se teme la posible
producción de armas biológicas por ser ésta tan potente que solamente 75 nanogramos -a
una dosis semiletal de 1 ng/kg- pueden matar a una persona.4 De modo que una gota puede
matar a 13.333.333 personas y 550 gramos (aproximadamente medio kilo) sería suficiente
para matar a toda la población humana.
Patogenia[editar]
La bacteria produce la toxina botulínica únicamente en ambientes altamente deficientes de
oxígeno y cuyo pH no sea muy ácido (mayor de 4.6), razón por la cual es más frecuente
encontrarla en alimentos enlatados o cerrados. Cada uno de los siete subtipos del C.
botulinum produce una toxina botulínica diferente.5 En los Estados Unidos, por ejemplo, los
brotes son producidos principalmente debido a los subtipos A y B por ingesta de la toxina
botulínica preformada, o del tipo E, el cual se encuentra predominantemente en pescados.
Estos subtipos son identificados con letras desde la A hasta la G. Los subtipos C y D no son
patógenos humanos. La temperatura óptima para los tipos A y B es 35-40 °C y un pHmínimo
de 4,8, tomando 5 minutos a 100 °C para matar estos subtipos. La temperatura óptima para el
tipo E es 18-25 °C y un pH mínimo de 5,0, tomando 0.1 minutos a 100 °C para matar este
subtipo de C. botulinum.
De forma general, se puede decir que la patogenia comienza cuando el individuo consume la
bacteria y/o su toxina con el alimento, en cualquier caso la acción patógena la ejerce la toxina
y no la bacteria. Las toxinas entran inactivas en el organismo y necesitan la acción de
proteasas endógenas de este para activarse. A través de circulación sanguínea llegan a las
terminaciones neuromusculares, donde bloquean la liberación de Acetilcolina, lo que impide a
los músculos contraerse y produce una parálisis flácida, es decir, una parálisis en la que los
músculos no están contraídos, sino relajados.
Las cepas de C. botulinum que no producen la toxina botulínica son referidas
como Clostridium sporogenes.6 Las especies son filogenéticamente indistinguibles, por lo que
el C. sporogenes es a menudo usado como un modelo para el estudio de subtipos tóxicos.
Referencias[editar]
1. Volver arriba↑ Ryan KJ; Ray CG (editors) (2004). Sherris Medical Microbiology (4ª ed. edición).
McGraw Hill. ISBN 0-8385-8529-9.
2. Volver arriba↑ Madigan M; Martinko J (editors). (2005). Brock Biology of Microorganisms (11th
ed. edición). Prentice Hall. ISBN 0-13-144329-1.
3. Volver arriba↑ Erbguth, Frank J. (2004) (en inglés) «Historical notes on botulism, Clostridium
botulinum, botulinum toxin, and the idea of the therapeutic use of the toxin.» (abstracto)
en Movement Disorders, Volume 19, Issue S8, pp. S2–S6, marzo de 2004. Wiley Library
Online. Consultado el 4 de mayo de 2014.
4. Volver arriba↑ By Diane O. Fleming, Debra Long Hunt. Biological Safety: principles and
practices. ASM Press, 2000, p. 267.
�5. Volver arriba↑ Wells CL, Wilkins TD (1996). Botulism and Clostridium botulinum in: Baron's
Medical Microbiology (Baron S et al, eds.) (4th ed. edición). Univ of Texas Medical Branch. (via
NCBI Bookshelf) ISBN 0-9631172-1-1.
6. Volver arriba↑ Judicial Commission of the International Committee on Systematic Bacteriology
(1999) Rejection of Clostridium putrificum and conservation of Clostridium
botulinum and Clostridium sporogenes Opinion 69. International Journal of Systematic
Bacteriology. 49, 339.